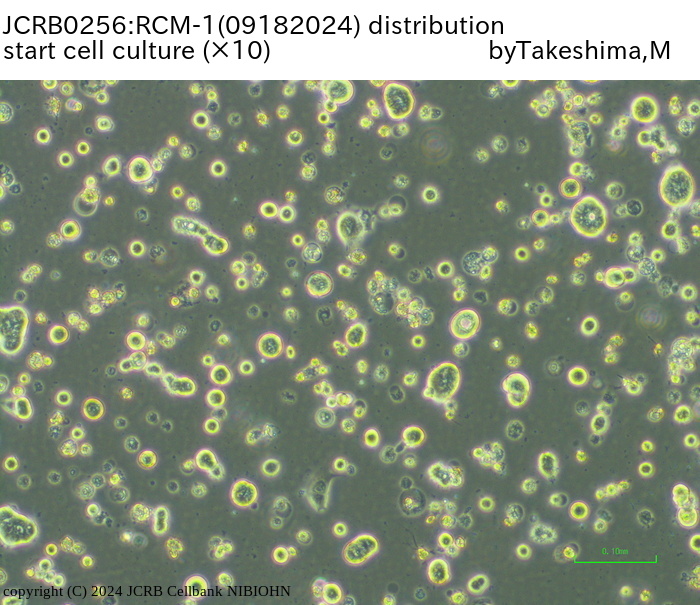

JCRB0256 RCM-1
Cell information
Cell type:general cells (View Pricing Information)
| JCRB No. | JCRB0256 | Cell Name | RCM-1 |
|---|---|---|---|
| Profile | adenocarcinoma, well differentiated | Other Name | |
| Animal | human | Strain | |
| Genus | Homo | Species | sapiens |
| Sex | Age | ||
| Identity | available | Tissue for Primary Cancer | rectum |
| Case history | Metastasis | ||
| Tissue Metastasized | Genetics | rectum, adenocarcinoma, well differentiated | |
| Life Span | Crisis PDL | ||
| Morphology | Character | rectum, adenocarcinoma, well differentiated | |
| Classify | Established by | Kataoka,H. | |
| Registered by | Kataoka, H. | Regulation for Distribution | Please send a reprint to Kataoka, H. |
| Comment | 73 year-old, female. Partially mucinous. Secrete proteinase inhibitors, and CEA etc. | Year | 1989 |
| Medium | 45% RPMI1640 medium with 45% Ham's F12 medium and 10% fetal calf serum | Methods for Passages | 0.02% EDTA and 0.125% trypsin. Subculture after observation of dome formation. Dome is induced |
| Cell Number on Passage | split ratio=1/4,every 2-3 wks | Race | |
| CO2 Conc. | 5 % | Tissue Sampling | rectum |
| Tissue Type |
| Detection of virus genome fragment by Real-time PCR | |||||||||
|---|---|---|---|---|---|---|---|---|---|
| Detected DNA Virus | tested | Detected RNA Virus | tested | ||||||
| CMV | - | parvoB19 | - | HCV | - | HTLV-1 | - | ||
| EBV | - | HBV | - | HIV-1 | - | HTLV-2 | - | ||
| HHV6 | - | HTLV-1 | - | HIV-2 | - | HAV | - | ||
| HHV7 | - | HTLV-2 | - |
-/negative. +/positive. nt/not tested. (positive (+) does not immediately mean the production of infectious viral particles.) |
|||||
| BKV | - | HIV-1 | - | ||||||
| JCV | - | HIV-2 | - | ||||||
| ADV | - | HPV18 | NT | ||||||
| Notes | |||||||||
| Reference | |
|---|---|
| Pubmed id:3198327 | A new long-term in vitro invasion assay using fibrous connective tissue matrices maintaining architectural characteristics of connective tissue. Nabeshima K,Kataoka H,Koita H,Murayama T,Koono M Invasion Metastasis. 1988;8(5):301-16 |
| Images |
|---|
               |
| Movies |
|---|

|
LOT Information
Viability/Growth rate/Cell number are represented as actual values measured at lot presentation in JCRB, but are not guaranteed values. Additionally, the doubling time is a rough value measured during passages.| Cell No. | JCRB0256 | Cell Name | |
|---|---|---|---|
| LOT No. | 09072005 | Lot Specification | distribution |
| Medium | 45% RPMI1640 medium and 45% Ham's F12 medium with 10% fetal bovine serum (FBS lot; GIBCO 4218333S) | Temperature | 37 C |
| Cell Density at Seeding | 2 - 7 x 10^5 cells/ml | Methods for Passages | 0.25% trypsin and 0.02% EDTA |
| Doubling Time | approx. 70 hrs | Cell Number in Vial (cells/1ml) | 3.1 x 10^6 |
| Viability at cell freezing (%) | 97.7 | Antibiotics Used | free |
| Passage Number | P69 | PDL | |
| Sterility: MYCOPLASMA | - | Sterility: BACTERIA | - |
| Sterility: FUNGI | - | Isozyme Analysis | Confirmed as human by NP, G6PD (type B), AST. |
| Chromosome Mode | Chromosome Information | ||
| Surface Antigen | DNA Profile (STR) | ||
| Adhesion | Yes | Exoteric Gene | |
| Medium for Freezing | 10% DMSO, 20% FBS - culture medium | CO2 Conc. | 5% |
| Viability immediately after thawing (%) | Additional information |
| Cell No. | JCRB0256 | Cell Name | |
|---|---|---|---|
| LOT No. | 091593 | Lot Specification | distribution |
| Medium | RPMI 1640 + Ham's F12 (1:1) + FCS 10% | Temperature | 37 |
| Cell Density at Seeding | 1/4 per 2-3 weeks | Methods for Passages | 0.02% EDTA and 0.125% trypsin. Subculture after observation of dome formation. Dome is induced |
| Doubling Time | Cell Number in Vial (cells/1ml) | 2.0 x 10^6 | |
| Viability at cell freezing (%) | NT | Antibiotics Used | free |
| Passage Number | P65 | PDL | |
| Sterility: MYCOPLASMA | - | Sterility: BACTERIA | - |
| Sterility: FUNGI | - | Isozyme Analysis | AST, G6PD, LD, MD, NP, PEPB |
| Chromosome Mode | Chromosome Information | ||
| Surface Antigen | DNA Profile (STR) | ||
| Adhesion | Exoteric Gene | ||
| Medium for Freezing | CO2 Conc. | ||
| Viability immediately after thawing (%) | Additional information |
| Cell No. | JCRB0256 | Cell Name | RCM-1 |
|---|---|---|---|
| LOT No. | 04252014 | Lot Specification | distribution |
| Medium | 1:1 mixture of RPMI1640 medium and Ham's F12 medium with 10% fetal bovine serum (FBS; GIBCO Cat. # 10091) | Temperature | 37 C |
| Cell Density at Seeding | 1.4 - 1.9 x 10^5 cells/mL | Methods for Passages | Cells were harvested after treatment with 0.25% trypsin and 0.02% EDTA. |
| Doubling Time | Cell Number in Vial (cells/1ml) | 3.7 x 10^6 | |
| Viability at cell freezing (%) | 90 | Antibiotics Used | free |
| Passage Number | P68 | PDL | |
| Sterility: MYCOPLASMA | - | Sterility: BACTERIA | - |
| Sterility: FUNGI | - | Isozyme Analysis | Confirmed as human by NP, G6PD (type B), MD. |
| Chromosome Mode | Chromosome Information | ||
| Surface Antigen | DNA Profile (STR) | D5S818:11,12 D13S317:10,12 D7S820:11,12 D16S539:11,12 VWA:20 TH01:9 AM:X TPOX:8,11 CSF1PO:10,12 |
|
| Adhesion | Yes | Exoteric Gene | |
| Medium for Freezing | 10% DMSO, 20% FBS - RPMI1640/Ham's F12 | CO2 Conc. | 5% |
| Viability immediately after thawing (%) | 90 | Additional information |
| Cell No. | JCRB0256 | Cell Name | RCM-1 |
|---|---|---|---|
| LOT No. | 01282021 | Lot Specification | distribution |
| Medium | 1:1 mixture of RPMI1640 medium and Ham's F12 medium with 10% fetal bovine serum (FBS; Sigma Cat. # 172012) | Temperature | 37 C |
| Cell Density at Seeding | 1.2 - 1.3 x 10^5 cells/mL | Methods for Passages | Cells were harvested after treatment with 0.125% trypsin. |
| Doubling Time | approx. 60 hrs. | Cell Number in Vial (cells/1ml) | 4.3 x 10^6 |
| Viability at cell freezing (%) | 95 | Antibiotics Used | free |
| Passage Number | P68 | PDL | |
| Sterility: MYCOPLASMA | - | Sterility: BACTERIA | - |
| Sterility: FUNGI | - | Isozyme Analysis | |
| Chromosome Mode | Chromosome Information | ||
| Surface Antigen | DNA Profile (STR) | ||
| Adhesion | Yes | Exoteric Gene | |
| Medium for Freezing | 10% DMSO, 20% FBS - RPMI1640/F-12 | CO2 Conc. | 5% |
| Viability immediately after thawing (%) | 93 | Additional information |
| Cell No. | JCRB0256 | Cell Name | RCM-1 |
|---|---|---|---|
| LOT No. | 09182024 | Lot Specification | distribution |
| Medium | 1:1 mixture of RPMI1640(GIBCO Cat#11875-093) and Ham's F12 medium (GIBCO Cat#11765-054) with 10% heat inactivated fetal bovine serum (Nichirei Cat. # 174112, Lot 20M00K) | Temperature | 37 C |
| Cell Density at Seeding | 2.1-8.5x10^4 cells/sq.cm | Methods for Passages | Cells were harvested after treatment with 0.125%trypsin(GIBCO) and 0.02% EDTA. |
| Doubling Time | NT | Cell Number in Vial (cells/1ml) | 2.4x10^6 |
| Viability at cell freezing (%) | 92 | Antibiotics Used | free |
| Passage Number | p69 | PDL | NT |
| Sterility: MYCOPLASMA | - | Sterility: BACTERIA | - |
| Sterility: FUNGI | - | Isozyme Analysis | NT |
| Chromosome Mode | NT | Chromosome Information | NT |
| Surface Antigen | NT | DNA Profile (STR) | D5S818:11,12 D13S317:10,12 D7S820:11,12 D16S539:11,12 VWA:20 TH01:9 AM:X TPOX:8,11 CSF1PO:10,12 |
| Adhesion | Yes | Exoteric Gene | NT |
| Medium for Freezing | BAMBANKER (NIPPON Genetics Co., LTD, cat # CS-02-001) | CO2 Conc. | 5% |
| Viability immediately after thawing (%) | 92 | Additional information |
| Images |
|---|
|